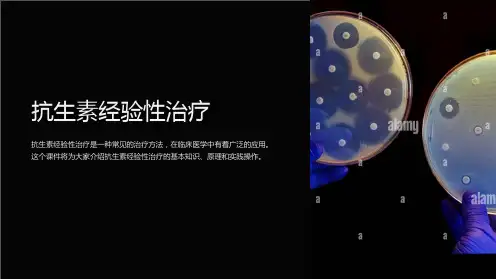

抗生素的经验性治疗76916
- 格式:ppt
- 大小:1.48 MB
- 文档页数:42

一、分类与联合用药(一)目的:提高抗菌疗效,延缓耐药,降低毒性。
(二)分类1、繁殖期杀菌药(1)β-内酰胺类①青霉素类a、青霉素G:(对B内酰胺酶不稳定,但对溶血链球菌所至呼吸道炎、猩红热、丹毒、峰窝织炎、盆腔炎、心内膜炎,对肺炎双球菌所致肺炎、鼻炎、中耳炎、对G+产气荚膜杆菌、破伤风、乳酸杆菌、百日咳、流感杆菌、钩体病、梅毒均有良好疗效,杀菌力强,毒性低。
b、耐酶青霉素:甲氧西林、苯唑西林、氯唑西林、双氯西林。
c、广谱青霉素:氨苄西林、羟苄西林、替卡西林、磺苄西林、呋苄西林、阿洛西林、美洛西林、哌拉西林。
d、复方青青霉素制剂:氨氯青霉素:氨苄西林与氯唑西林复合制剂,具两者优点。
舒氨西林(氨苄西林+舒巴坦);特治新(氨苄+克拉维酸)奥格门汀(阿莫西林+克拉维酸)力百汀(阿莫西林+克拉维酸)复方制剂加入了B内酰胺酶抑制剂,舒巴坦和克拉维酸无是不可逆的B内酰胺酶抑制剂,对B内酰胺酶有强大抑制作用,联合使用后能获得良好的协同作用,也扩大了抗菌谱。
不良反应:赫氏反应(小剂量开始),内毒素释放,青酶素脑病②头孢菌素类第一代特点:耐青霉素酶,对G+相当有效(包括耐酶金葡菌??),比2、3代强;对B内酰胺酶稳定性远较2、3代差;有肾毒性,与氨基甙或台利尿剂合用增加肾毒性;不易透过血脑屏障,不用于CNS感染;与氨基甙合用疗效差,不用于淋病、梅毒的治疗。
注射头孢噻吩头孢噻啶头孢唑林头孢拉定头孢硫咪口服头孢氨苄头孢拉定头孢羟氨苄第二代注射头孢孟多头孢呋辛头孢美唑、头孢西丁???、头孢替安、头孢替坦(前二者能透过血脑屏障,可用于化脑)口服头孢克洛头孢呋辛酯头孢替安酯第三代特点:抗菌活性强、广,对酶稳定;对绿有效,对G+不如第一代;有一定量渗入脑组织;对肾基本无毒性;作用时间长,毒性低。
三兄弟:他啶、哌酮(舒普深,加酶抑制剂,效果更好,胆汁浓度高)、曲松,对绿作用超过泰能,(特别是前二者)注射头孢噻肟头孢哌酮头孢曲松头孢唑肟头孢甲肟头孢他啶头孢唑南头孢米诺头孢咪唑头孢匹胺头孢磺啶头孢地嗪口服头孢克肟头孢布烯头孢地尼头孢他美酯头孢特仑酯头孢泊肟酯头孢妥仑酯第四代注射:头孢吡肟(马斯平)、头孢匹罗、头孢克定。



论抗菌药物的经验性治疗孙红伟于珠雨吴全学(原阳县人民医院药剂科河南新乡453500)摘要:在致病菌未明确前,临床医师往往首先为患者实施“抗菌药物经验性治疗”,然后再参考病原学检查结果与用药疗效,决定维持或调整药物治疗方案。
但滥用现象仍时有发生,本文将就如何使其更加科学合理作肤浅论述。
关键词:抗菌药物;经验性治疗;合理应用合理应用抗菌药物的关键是明确致病菌的种类和药敏并针对性地选用最合适的药物及治疗方案。
但细菌培养和药敏试验需数天出结果,在致病菌尚未明确前,为及时治疗感染性疾病,医师通常根据患者临床资料先大致推断最可能的致病菌,并给予“抗菌药物经验性治疗”。
但这种经验性用药决不能随心所欲,否则不仅会降低疗效,增加毒副反应,而且会助长细菌耐药,导致二重感染或药源性疾病,给病人的健康与生命带来危害。
如何使经验性治疗远离“摸着石头过河的试验性治疗”和盲目滥用的怪圈呢?下面笔者就根据在我院药师查房工作中所遇到的问题谈几点看法:1. 详细诊查,明确临床诊断,判断是否为感染性疾病及其类型,并配合其它辅助抗感染措施。
1. 1 错误的临床诊断必然伴随错误的治疗方案,并为滥用抗菌药物推波助澜。
首先应认真执行诊疗常规和临床路径,千方百计明确临床诊断,科学分析把握病情,排除非感染性疾病,进一步分清是病毒还是细菌等其它病原体感染,细菌感染方有抗菌药物应用指征;医师收住患者用药前应首先采集有代表性的临床标本如血、痰、尿、脑脊液、脓液等尽快送检,做到有样必采,力求尽早明确致病菌的种类和药敏等依据。
通过详细的问诊查体结合影像学检查,发热类型,血、尿、便三大常规以及CRP检查可初步判断是否为细菌感染。
根据感染的部位、性质、患者的年龄、性别、病史、用药史、临床特征与初步的检查化验结果,估计病原菌的大致类型,及可能对哪些抗菌药敏感,结合本地细菌耐药状况选择最恰当的药物,合理制定用药方案。
1. 2 在呼吸道感染、尿路感染、败血症及脑膜炎患者诊疗时,为尽快了解感染细菌的大概类型,可以先对采集的痰、尿、血、脑脊液作涂片染色镜检,初步观察有无细菌存在,是革兰氏阳性菌、阴性菌或是混合感染?根据细菌形态快速判断其类型,有的细菌如肺炎链球菌、流感嗜血杆菌、脑膜炎双球菌、金黄色葡萄球菌等具有典型的形态,在涂片染色镜检时就能识别出来,可以此作参考选择抗菌谱能够覆盖这些细菌的药物作经验治疗。




合理应用抗菌药张永信复旦大学附属华山医院传染病学教研室抗生素研究所抗菌药是临床上最常用的药物,其治疗细菌感染和细菌性传染病的疗效确切,为各科医生广泛应用。
然而,滥用抗菌药的现象十分普遍,这不仅使疗效降低,而且增加了药物的毒副反应,加重了细菌耐药性,甚至丧失治疗和抢救的时机,给病人的健康与生命带来危害。
合理用药的关键是针对致病菌选用最合适的药物。
因此,对中度、重度细菌感染,在应用抗菌药物前必须先收集临床标本如血、痰、尿、脑脊液、脓液做细菌培养,想方设法尽早明确致病菌的种类,并测定其药敏。
当致病菌明确时,可选择抗菌作用强、毒性低的品种用于临床,常可获得满意疗效。
然而,临床上大多数情况为致病菌尚未明确或病情危急,或属轻症感染时,可根据感染的部位、获得的途径、患者的年龄、病史与临床特征等先作经验治疗。
经验治疗的方案针对引起感染最可能的致病原。
本期刊登的一组专题笔谈涉及临床常见细菌感染的经验用药,其实用性强。
读者可结合本地各种感染常见致病菌的种类及其药敏状况作相应的调整。
经验用药若取得良好疗效,一般可继续用药直至痊愈。
若疗效不满意,可根据细菌培养的结果和药敏试验调整用药。
总之,尽早确定致病原是合理用药最重要的前提,各级医院均应建立良好的细菌学诊断常规,并予以认真落实。
供临床选用的抗菌药品种繁多,临床医生应善于将每一种药物最突出的药理特点用于治疗,以取得最佳疗效。
药物独特的抗菌谱与抗菌作用往往决定其主要的适应证。
此外,尽量选择安全、毒性低,有足够浓度的药物到达感染部位也很重要。
联合用药主要限于单一抗菌药难以控制的严重感染或混合感染、病原菌不明的严重感染、易产生耐药的感染,以及药物毒性大通过联合用药减少剂量,或药物在感染部位的浓度低、联合易渗入该组织的品种。
因此,联合用药的指征更加严格。
联合用药的目的在于增强抗菌作用,提高疗效。
临床上宜以繁殖期杀菌剂(如β—内酰胺类)与静止期杀菌剂(如氨基糖苷类)联合,常获协同作用;而避免繁殖期杀菌剂与快速制菌剂(四环素、氯霉素类、大环内酪类)联合,以防拮抗可能。